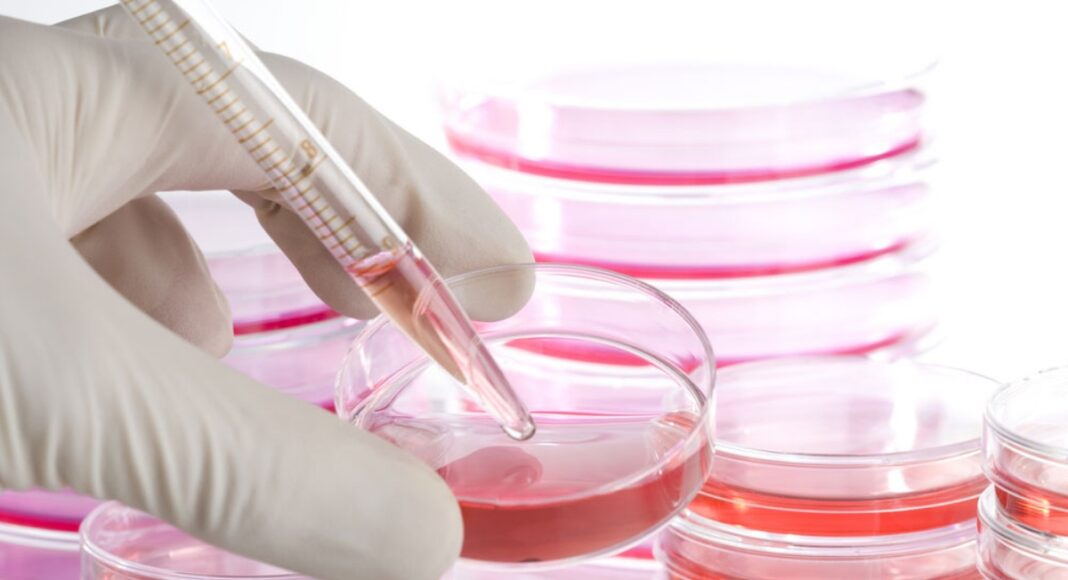

Κινέζοι ερευνητές ανέπτυξαν μια νέα θεραπεία με βλαστοκύτταρα για τη νόσο Πάρκινσον, η οποία, σύμφωνα με τις αναφορές τους, προσφέρει ταχεία βελτίωση των συμπτωμάτων σε ασθενείς που πάσχουν εδώ και δεκαετίες από τη νευρολογική διαταραχή.
Η νόσος Πάρκινσον είναι μια προοδευτική νευρολογική πάθηση που επηρεάζει κυρίως την κινητικότητα του σώματος και προκαλείται από τον θάνατο νευρικών κυττάρων σε περιοχή του εγκεφάλου που παράγει τη ντοπαμίνη, μια βασική ορμόνη για τον έλεγχο της κίνησης. Με την πάροδο του χρόνου, οι ασθενείς μπορεί να εμφανίσουν γενικευμένη δυσκαμψία και να καταστούν πλήρως ανίκανοι να αυτοεξυπηρετηθούν.
Η εκφυλιστική αυτή νόσος δεν έχει ακόμη οριστική θεραπεία και οι διαθέσιμες θεραπευτικές επιλογές επικεντρώνονται κυρίως στην αντιμετώπιση των συμπτωμάτων. Πολλές από τις υπάρχουσες προσεγγίσεις επιχειρούν να αναπληρώσουν προσωρινά τη ντοπαμίνη στον εγκέφαλο, χωρίς όμως να αντιμετωπίζουν τη βασική αιτία του προβλήματος, δηλαδή τον θάνατο των νευρώνων.
Τώρα, ερευνητές από το Πρώτο Συνεργαζόμενο Νοσοκομείο του Πανεπιστημίου Επιστήμης και Τεχνολογίας της Κίνας (USTC) υποστηρίζουν ότι πέτυχαν υψηλή αποτελεσματικότητα με τη θεραπεία τους με βλαστοκύτταρα, βοηθώντας ασθενείς με Πάρκινσον να ανακτήσουν χαμένες κινητικές λειτουργίες.
Από τον Απρίλιο, οι επιστήμονες πραγματοποιούν κλινική δοκιμή Φάσης Ι, στο πλαίσιο της οποίας μεταμόσχευσαν βλαστοκύτταρα σε έξι ασθενείς, καταγράφοντας ταχεία υποχώρηση των συμπτωμάτων και σταθερή ενίσχυση της ντοπαμινεργικής σηματοδότησης στον εγκέφαλο των συμμετεχόντων. Στόχος της θεραπείας είναι να ωθήσει τα εγχυόμενα βλαστοκύτταρα να διαφοροποιηθούν και να μετατραπούν σε νευρικά κύτταρα που εκκρίνουν αποκλειστικά ντοπαμίνη.
Οι ερευνητές δήλωσαν ότι κατάφεραν να επιτύχουν πολύ υψηλό ποσοστό διαφοροποίησης των βλαστοκυττάρων σε λειτουργικά κύτταρα παραγωγής ντοπαμίνης.
«Τα “φυτεύουμε” στον εγκέφαλο του ασθενούς και τα αφήνουμε να διαφοροποιηθούν σε ολοκαίνουργιους ντοπαμινεργικούς νευρώνες, οι οποίοι αναδιαμορφώνουν τα νευρωνικά δίκτυα του εγκεφάλου», δήλωσε στη SouthChinaMorningPost ο νευρολόγος Σι Τζιονγκ, μέλος της ερευνητικής ομάδας.
«Διεθνώς κορυφαίες ομάδες έχουν πρόσφατα αναφέρει ποσοστά μετατροπής γύρω στο 50%, όμως η δική μας ομάδα πέτυχε ποσοστό άνω του 80% μέσα από μια σειρά συντονισμένων προσπαθειών», σημείωσε ο Δρ. Τζιονγκ.
Ένας από τους έξι συμμετέχοντες στη μελέτη φέρεται να παρουσίασε εντυπωσιακή μείωση συμπτωμάτων όπως το τρέμουλο και η μυϊκή δυσκαμψία.
Σύμφωνα με τους ερευνητές, η βαθμολογία του 37χρονου ασθενούς στην Κλίμακα Αξιολόγησης της Νόσου Πάρκινσον μειώθηκε από 62- επίπεδο που αντιστοιχεί σε σοβαρή αναπηρία- σε 12, ιμή σχεδόν αντίστοιχη με αυτή ενός υγιούς ατόμου.
Οι ερευνητές ελπίζουν να στρατολογήσουν περισσότερους ασθενείς για μελέτες μεγαλύτερης κλίμακας, ώστε να διερευνηθεί περαιτέρω η αποτελεσματικότητα της νέας θεραπείας.